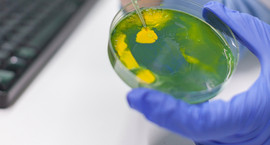

Biology
Biology Programs
Biology, B.S.
Biology, Minor
Outcomes Driven Education


B.S., Biology


B.S. Biology, McGuire Scholar


BS Biology


Maimonides Medical Center
“I have held leadership roles as president of the Pre-Med Club and SFC’s chapter of the TriBeta Biological Honor Society, while also serving as secretary of the Environmental Club.”
“[Dr. Ruiz] said that I need to believe in myself and do this for myself.. I will remember her saying that to me for the rest of my life, because it's completely true.”
“What I experienced at St. Francis College is priceless. It has enabled me to develop a Franciscan spirit, and I view that as an accomplishment.”
“When I was looking around for colleges, a few caught my eye, but none of them had the feel that I wanted, aside from St. Francis.”
Biology News and Events
St. Francis College Among Recipients of Grant to Increase Diversity in STEM Fields
Inaugural Science-Related Career Conference, Hosted by the STEM Resource Center, a Resounding Success
Request More Information